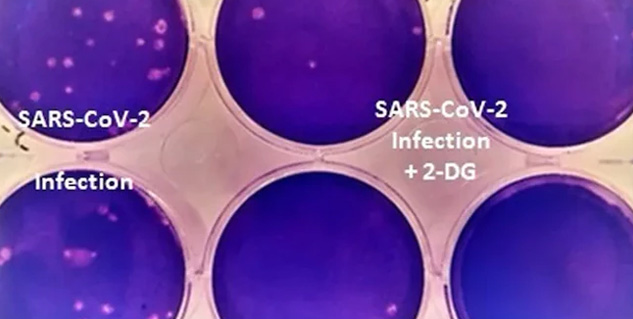
Inside2_DRDOdevelopedcovidmedicine

कोरोना को मात देने के लिए तरह-तरह की दवाओं पर एक्सपेरीमेंट चल रहे हैं। इसी बीच पिछले दिनों भारत के रक्षा अनुसंधान एवं विकास संगठन (DRDO ) ने कोविड रोधी दवा बनाकर लोगों के बीच उम्मीद की किरण पैदा कर दी है। इस दवा को भारत के औषधि महानियंत्रक (डीसीजीआई) ने आपात इस्तेमाल की मंजूरी दे दी है। रक्षा मंत्रालय ने बयान जारी कहा था कि यह दवा पाउडर के रूप में होगी जो पानी में घोलकर मरीजों को दी जाएगी। अभी तक इंजेक्शन और गोलियों के रूप में कोविड मरीजों को दवा दी जा रही थी, लेकिन अब DRDO द्वारा विकसित 2-deoxy-D-glucose (2-DG) दवा बिना किसी दर्द के मरीज को दी जा सकेगी।
इस पेज पर:-
विशेषज्ञों का कहना है कि टू-डियोक्सी-डी-ग्लूकोज यानी 2-डीजी दवा कोरोना के माइल्ड से लेकर गंभीर मरीजों तक को फायदा पहुंचाएगी। साथ ही डीआरडीओ का कहना है कि यह दवा ऑक्सीजन पर निर्भरता भी कम करेगी। कोरोना को मात देने वाली इस नई दवा के बारे में लोगों के मन में बहुत से सवाल हैं, आपके हर सवाल का जवाब यहां स्वामी दयानंद अस्पताल में जनरल फिजिशियन डॉक्टर ग्लैडविन त्यागी दे रहे हैं। उन्होंने बताया कि कोरोना की यह नई दवा कोरोना मरीजों में ग्लूकोज के अपटेक को रोक देगी, जिससे वायरस को ग्लूकोज नहीं मिलता और वह मर जाता है। इस दवा के बारे में बाकी जानकारी विस्तारपूर्वक उन्होंने दी।
2-डीजी दवा किसने बनाई?
इसकी जानकारी डीआरडीओ ने ट्वीट करके दी है। उन्होंने बताया है कि यह 2-deoxy-D-glucose (2-DG) ड्रग डीआरडीओ के इंस्टीट्यूट ऑफ न्यूक्लीअर मेडिसिनएंड एलाइड साइंसिज (INMAS) ने हैदराबाद की डॉक्टर रैड्डी लैबोरेटरीज के साथ मिलकर बनाई है।
An anti-COVID-19 therapeutic application of the drug 2-deoxy-D-glucose (2-DG) has been developed by INMAS, a lab of DRDO, in collaboration with Dr Reddy’s Laboratories, Hyderabad. The drug will help in faster recovery of Covid-19 patients. https://t.co/HBKdAnZCCP pic.twitter.com/8D6TDdcoI7
— DRDO (@DRDO_India) May 8, 2021
यह दवा कोरोना पर कैसे काम करती है?
दिल्ली के स्वामी दयानंद अस्पताल में जनरल फिजिशियन डॉक्टर ग्लैडविन त्यागी ने बताया कि हमारे शरीर की कोशिकाओं में जो ग्लूकोज के अपटेक होते हैं, ये दवा उस अपटेक को रोक देती है, जिसकी वजह से वायरस को ग्लूकोज नहीं मिलता है तो वह मर जाता है। इस तरह से ये दवा काम करती है। इस दवा के प्रयोग से मरीजों को अस्पताल में भर्ती होने से बचाया जा सकेगा और ऑक्सीजन पर निर्भरता कम होगी। लेकिन डॉक्टर का यह भी कहना है कि अभी तक ये दवा बाजार में आई नहीं है तो मरीजों पर कैसे काम करेगी इस पर कुछ कहा नहीं जा सकता। डॉक्टर ने बताया कि पहले वाला कोरोना इतना गंभीर नहीं था जितना इस साल का है, इसलिए ये ड्रग बाजार में आने के बाद इसके प्रभाव के बारे में कुछ कहा जा सकता है।
इसे भी पढ़ें : कोरोना की तीसरी लहर हो सकती है खतरनाक, 4 हेल्थ एक्सपर्ट्स से जानें कैसे रखें बचाव की तैयारी

2-डीजी के क्लिनिकल ट्रायल कब-कब हुए?
2-डीजी ड्रग के लिए पिछले साल साल मई और अक्तूबर के बीच में फेज-2 के क्लीनिकल ट्रायल हुए थे। दूसरे ट्रायल में 110 लोगों को शामिल किया गया था। दूसरे ट्रायल के पहले चरण में 6 अस्पतालों और 11 अस्पतालों को दूसरे ट्रायल के दूसरे चरण में शामिल किया गया था। इस दवा के सेवन से मरीजों ने जल्दी रिकवरी की थी। 2-डीजी के तीसरे क्लीनिकल ट्रायल का अप्रूवल पिछले साल नवंबर में दिया गया था। ये ट्रायल 27 कोविड अस्पतालों में किए गए थे। इनमें दिल्ली, उत्तर प्रदेश, पश्चिम बंगाल, गुजरात, राजस्थान, महाराष्ट्र, आंध्र प्रदेश, तेलंगाना, कर्नाटक और तमिलनाडु शामिल हैं।
इसे भी पढ़ें : क्या कोरोना मरीजों के लिए एक जरूरी दवा है रेमडेसिविर इंजेक्शन? डॉक्टर से जानें इसके बारे में
क्या यह दवा ऑक्सीजन पर निर्भरता कम करती है?
डीआरडीओ ने दावा किया है कि यह दवा ऑक्सीजन पर निर्भरता कम करती है। इस दवा को खाना आसान है। पिछले साल जो ट्रायल हुए उनमें भी यह डेटा निकलकर आया कि कोविड के मोडरेट केसिस में ऑक्सीजन पर निर्भरता कम करती है यहां तक कि 65 साल से ऊपर वाले मरीजों में भी यह दवा ऑक्सीजन को ठीक रखती है।
क्या 2-डीजी का महत्त्वपूर्ण प्रभाव पड़ेगा?
डीआरडीओ का कहना है कि 2-डियोक्सी-डी-ग्लूकोज (2-डीजी) को आसानी से उत्पादन किया जा सकता है और देश में आसानी से मिल पाएगा। डीआरडीओ का दावा है कि यह दवा जेनेरिक मॉलिक्यूल और ग्लूकोज का एनालोग (analogue of glucose) है।
कोरोना की यह नई दवा 2-deoxy-D-glucose (2-DG) लोगों के लिए उम्मीद लेकर आई है। जैसा कि हम सभी जानते हैं कि कोरोना की तीसरी लहर भी आने वाली है, ऐसे में कोरोना को लेकर यह सभी तैयारियां उम्मीद को जगाती हैं।
Read more articles on Miscellaneous in Hindi
यह विडियो भी देखें
How we keep this article up to date:
We work with experts and keep a close eye on the latest in health and wellness. Whenever there is a new research or helpful information, we update our articles with accurate and useful advice.
Current Version